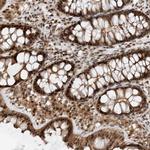
TATDN3 Antibody in Immunohistochemistry (Paraffin) (IHC (P))

Search
Invitrogen
TATDN3 Polyclonal Antibody
{{$productOrderCtrl.translations['antibody.pdp.commerceCard.promotion.promotions']}}
{{$productOrderCtrl.translations['antibody.pdp.commerceCard.promotion.viewpromo']}}
{{$productOrderCtrl.translations['antibody.pdp.commerceCard.promotion.promocode']}}: {{promo.promoCode}} {{promo.promoTitle}} {{promo.promoDescription}}. {{$productOrderCtrl.translations['antibody.pdp.commerceCard.promotion.learnmore']}}

Please note: We are reviewing Western blot images included in the antibody testing data in our catalog, including those provided by third parties. Unless expressly labeled or annotated as “raw-unedited”, Western blot images included in the antibody testing data in our catalog may have been edited, optimized or otherwise adjusted for presentation.
产品信息
PA5-56922
种属反应
宿主/亚型
分类
类型
抗原
偶联物
形式
浓度
规格
纯化类型
保存液
内含物
保存条件
运输条件
RRID
产品详细信息
Immunogen sequence: AGVGLVDCHC HLSAPDFDRD LDDVLEKAKK ANVVALVAVA EHSGEFEKIM QLSERYNGFV LPCL
Highest antigen sequence identity to the following orthologs: Mouse - 88%, Rat - 28%.
靶标信息
The TATDN3 gene encodes the protein TatD DNase domain containing 3, which belongs to a family of nucleases with a range of enzymatic activities. TATDN3 is known to exhibit apurinic/apyrimidinic (AP) endonuclease activity, which is crucial for DNA repair mechanisms, particularly in the recognition and removal of damaged bases. Structurally, the TatD family proteins, including TATDN3, possess a conserved nuclease domain that enables their function in DNA metabolism. Studies demonstrate that TATDN3 can also display 3'-5' exonuclease activity, further contributing to genome stability by processing DNA ends. Phylogenetically, TATDN3 represents a distinct clade with unique active site motifs, differentiating it from other paralogs such as TATDN1. Given its involvement in critical cellular processes, TATDN3 is an important factor in maintaining genomic integrity and preventing mutations that may lead to diseases such as cancer.
仅用于科研。不用于诊断过程。未经明确授权不得转售。
篇参考文献 (0)
生物信息学
蛋白别名: Deoxyribonuclease TATDN3; DNA-(apurinic or apyrimidinic site) endonuclease TATDN3; TatD DNase domain containing 3
基因别名: TATDN3
Entrez Gene ID: (Human) 128387




